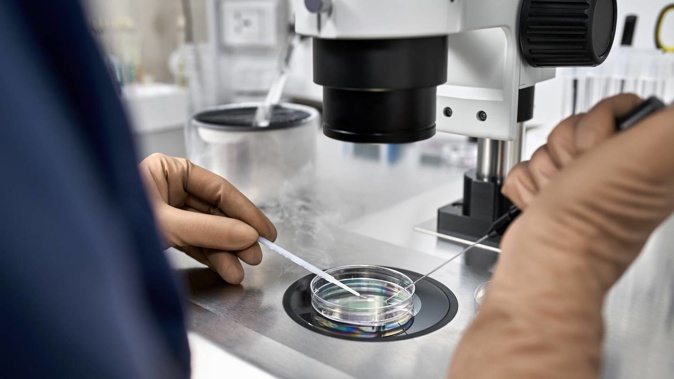
Scientists said the lab-grown eggs opened up new possibilities for fertility preservation and the treatment of infertility. Photo / 123RF

Human eggs grown in the lab could help women have children later in life – and may replace traditional IVF within a generation, a leading scientist has said.Â
Researchers are preparing to start testing the technique in sheep, with human trials anticipated within five to 10 years.Â
Experts said the method could spare women the hormonal rollercoaster of existing fertility treatments.Â
They also suggested the controversial technique could allow women to start families at an older age and be offered to LBGT and transgender patients.Â
"Lab-grown eggs open up new possibilities for fertility preservation and the treatment of infertility, and they would provide options for a wider group of patients," said Professor Evelyn Telfer, lead researcher of the study at the University of Edinburgh.Â
It follows warnings that too many older women are being offered fertility treatment without being told that their chance of having a baby using their own eggs is vanishingly small – with success rates as low as 1 per cent among those aged 44 and over.Â
As a result, increasing numbers are turning to donor eggs.Â
Figures from the Human Fertilisation and Embryology Authority (HFEA) show that in 2019, three in five women having IVF over the age of 45 used eggs that were donated.Â
The new technique, which is being developed by researchers at Edinburgh and Leeds universities, involves doctors taking a small ovarian tissue biopsy from a young woman or girl and freezing it until they want to start a family, when cells will be stimulated in the lab to produce mature eggs ready for fertilisation.Â
While scientists are unable to say yet how reliable these lab-grown eggs will be, there is hope that using younger tissue to produce eggs may help improve older women's chances of having a successful pregnancy.Â
IVF success decreases with ageÂ
More than half of patients undergoing IVF cycles are now over 35, with one in five aged over 40, according to the HFEA.Â
But after the age of 40 the chance of success reduces significantly. Among women aged 42 to 43 using their own fresh eggs, there is a success rate of 3 per cent, which drops to just 1 per cent after the age of 44.Â
The development of the new treatment is currently focused on preserving the fertility of girls with childhood cancer ahead of chemotherapy or radiotherapy, which can render them infertile.Â
But scientists hope it could also be used to create donor eggs, as well as helping women who have fertility issues, who want to postpone motherhood or who are transitioning gender but want to be able to have their own biological children in future.Â
Edinburgh researchers have already grown human eggs in the lab but trials have yet to establish if such eggs can be fertilised, lead to pregnancy and result in a healthy baby.Â
Now they have teamed up with the University of Leeds and are preparing to embark on such trials in sheep, starting within the next year. If these are successful, human trials will follow.Â
Other studies have shown lab grown eggs can lead mice to give birth to healthy babies.Â
Prof Telfer said she expected the treatment to be available to the young girls of today by the time they are ready to have children.Â
She said, in time, the process could replace traditional IVF and save women from some of the most physically demanding aspects of fertility treatments.Â
Currently, women undergoing treatment - including egg freezing - must give themselves daily hormone injections to artificially stimulate egg production within their bodies.Â
This hormonal influx can cause headaches, hot flushes and low mood - and risks triggering ovarian hyperstimulation syndrome, which can lead to dangerous blood clots and breathing difficulties.Â
"This process of lab-grown eggs – or as we refer to it as 'in vitro growth' – could replace conventional IVF … There are advantages to that because it bypasses the hormonal stimulation that is required for cycles of IVF to retrieve eggs," she told an event hosted by the fertility research charity Progress Educational Trust (PET).Â
The last decade has seen a tenfold rise in the use of egg freezing in the UK, but the process means women have to undergo hormonal stimulation, and has shown mixed results. Across all age groups, only around only one in seven IVF cycles using frozen eggs leads to a live birth, compared with one in four using fresh eggs.Â
Professor Helen Picton, who is leading the research at Leeds University, described the new research as "a story full of hope" for women.Â
Commenting on the plans to start trials in sheep next year, she said: "I would hope everything we are doing now will give us the answers we are looking for within the next few years - that is a really big milestone for progressing to the next stage with human therapies."Â
But she warned that the technique needed to be further developed before it could become a simple alternative to IVF, as the current method of extracting ovarian tissue required keyhole surgery under general anaesthetic, which is more invasive than existing egg collection methods.Â
Sarah Norcross, the PET director, said: "It is extremely challenging to develop human egg cells in the laboratory, but recent research in this area shows promise. Eggs grown in vitro could help a number of patient groups.Â
"The safety and efficacy of using such lab-grown eggs will have to be rigorously tested before they can be used to try to achieve a pregnancy. If such tests are satisfied, and if lab-grown eggs are used successfully in treatment, then they might eventually be used more widely – to help women who wish to avoid the hormonal stimulation part of an IVF cycle, as well as for women with Turner syndrome [a genetic condition] and transgender patients."Â
- by Laura Donnelly and Rosie Taylor, Daily Telegraph UK
Take your Radio, Podcasts and Music with you